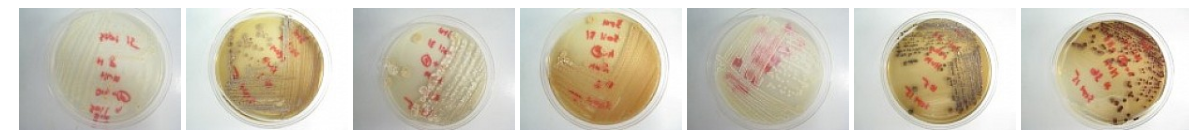

Antimicrobial Discovery
To effectively address antibiotic resistance, we need to discover new antibiotics and antimicrobial strategies. Our group is approaching this in several ways with an emphasis of using Chemical Biology and Chemical Genetics strategies and in particular emphasizing microbial natural products as sources of new bioactive chemical matter. We are focused on bacterial, fungal and malarial parasite pathogens to this end.
Antibiotic Adjuvants
Compounds that improve the activity of antibiotics for example increasing potency, blocking resistance, etc. are termed antibiotic adjuvants. We are screening synthetic and natural product compounds for their ability potentiate antibiotics in a number of assays including direct inhibition of known resistance mechanisms, increasing activity of antibiotics against Gram negative bacteria among others.
Selected Publications
Authors: Koteva K, Sychantha D, Rotondo CM, Hobson C, Britten JF, Wright GD.
Reference: ACS Omega.
DOI: 10.1021/acsomega.1c05757.
PMID: 35155911.
Authors: Sychantha D, Rotondo CM, Tehrani KHME, Martin NI, Wright GD.
Reference: J Biol Chem.
DOI: 10.1016/j.jbc.2021.100918.
PMID: PMC8319579.
Authors: Yarlagadda V, Medina R and Wright GD
Reference: Sci Rep.
DOI: 10.1038/s41598-020-64756-0
PMID: 32424122
Authors: Rotondo CM, Sychantha D, Koteva K and Wright GD
Reference: Antimicrob Agents Chemother.
DOI: 10.1128/AAC.01386-19
PMID: 31932375
Authors: CM Rotondo and GD Wright
Reference: Current Opinion in Microbiology 2017 39: 96-105
PMID: 29154026
Authors: Cox G, Sieron A, King AM, De Pascale G, Pawlowski AC, Koteva K, Wright GD.
Reference: Cell Chem Biol. 2016 Nov 29. pii: S2451-9456(16)30434-2. doi: 10.1016/j.chembiol.2016.11.011.
PMID: 28017602
Authors: Nicole Robbins, Michaela Spitzer, Tennison Yu, Robert P Cerone, Anna K Averette, Yong-Sun Bahn, Joseph Heitman, Donald C Sheppard, Mike Tyers, Gerard D Wright
Reference: Cell Rep. 2015 Nov 17;13(7):1481-92. doi: 10.1016/j.celrep.2015.10.018.
PMID: 26549450
Authors: Andrew M King, Sarah A Reid-Yu, Wenliang Wang, Dustin T King, Gianfranco De Pascale, Natalie C Strynadka, Timothy R Walsh, Brian K Coombes, Gerard D Wright
Reference: Nature. 2014 Jun 26;510(7506):503-6. doi: 10.1038/nature13445.
PMID: 24965651
Novel therapeutic leads
Antibiotics that kill a broad spectrum of bacteria are not the only strategy to treat infection. Reducing the virulence of pathogens, improving the reactivity of the host innate immune response, and the discovery of highly narrow spectrum antimicrobials are others. Here we are screening natural products in particular and combinations of agents for these desired phenotypes.
Selected Publications
Authors: Yarlagadda V, Rao VN, Kaur M, Guitor AK, Wright GD.
Reference: ACS Infect Dis.
DOI: doi: 10.1021/acsinfecdis.1c00040.
PMID: 33826296.
Authors: Yarlagadda V, Medina R, Johnson TA, Koteva KP, Cox G, Thaker MN, Wright GD.
Reference: ACS Infect Dis.
DOI: 10.1021/acsinfecdis.0c00467
PMID: 33164482
Authors: Culp EJ, Waglecher N, Wang W, Fiebig-Comyn AA, Hsu Y, Koteva K, Sychantha D, Coombes BK, Van Nieuwenhze MS, Brun YV and Wright GD
Reference: Nature
DOI: 10.1038/s41586-020-1990-9
PMID: 32051588
Authors: Culp EJ, Yim G, Waglechner N, Wang W, Pawlowski AC and Wright GD
Reference: Nat Biotechnol.
DOI: 10.1038/s41587-019-0241-9
PMID: 31501558
Authors: Cox G, Ejim L, Stogios PJ, Koteva K, Bordeleau E, Sieron AO, Savchenko A, Serio AW, Krause KM, Wright GD
Reference: ACS Infectious Diseases 2018
DOI: 10.1021/acsinfecdis.8b00001
PMID: 29634241
Authors: Robbins N, Spitzer M, Wang W, Waglechner N, Patel DJ, O'Brien JS, Ejim L, Ejim O, Tyers M, Wright GD.
Reference: Cell Chem Biol. 2016 Nov 17;23(11):1383-1394. doi: 10.1016/j.chembiol.2016.08.015.
PMID: 27746129
Authors: Perry JA, Koteva K, Verschoor CP, Wang W, Bowdish DM, Wright GD.
Reference: J Antibiot (Tokyo). 2015 Jan;68(1):40-6. doi: 10.1038/ja.2014.83.
PMID: 24984798
Synthetic Biology to increase antimicrobial chemical diversity
Natural products are proven to be excellent leads for new antibiotics and other therapeutics. They represent privileged chemical matter with intrinsic bioactivity. Exploring and expanding this chemical matter is readily amenable to synthetic biology strategies. We are exploring antimicrobial natural product biosynthetic mechanism and endeavoring to use tailoring enzymes to expand the chemical diversity of several scaffolds.
Selected Publications
Authors: Xu M, Wang W, Waglechner N, Culp EJ, Guitor AK, Wright GD.
Reference: Nat Commun.
DOI: 10.1038/s41467-020-19138-5
PMID: 33067466
Authors: Xu M, Wright GD
Reference: J Ind Microbiol Biotechnol.
DOI: 10.1007/s10295-018-2097-2
PMID: 30446891
Authors: G Yim, W Wang, MN Thaker, S Tan, GD Wright
Reference: ACS Infect. Dis., 2016, 2 (9), pp 642–650 DOI: 10.1021/acsinfecdis.6b00105
Authors: Maulik N Thaker, Wenliang Wang, Peter Spanogiannopoulos, Nicholas Waglechner, Andrew M King, Ricardo Medina, Gerard D Wright
Reference: Nat Biotechnol. 2013 Oct;31(10):922-7. doi: 10.1038/nbt.2685.
PMID: 24056948
A Focus on Microbial Natural Products: The WAC Library
Living organisms have proven to be the most reliable source of bioactive chemicals with antimicrobial activity. Environmental microbes continue to be outstanding resources for the identification of new chemical scaffolds that perturb microbial biology. We are searching for new bioactive agents derived from these sources as starting points for new antimicrobial agents and to facilitate this we have established the Wright Actinomycete Collection (WAC). This library includes approximately 10,000 strains collected from a myriad of environments and includes over 25 distinct genera.


















